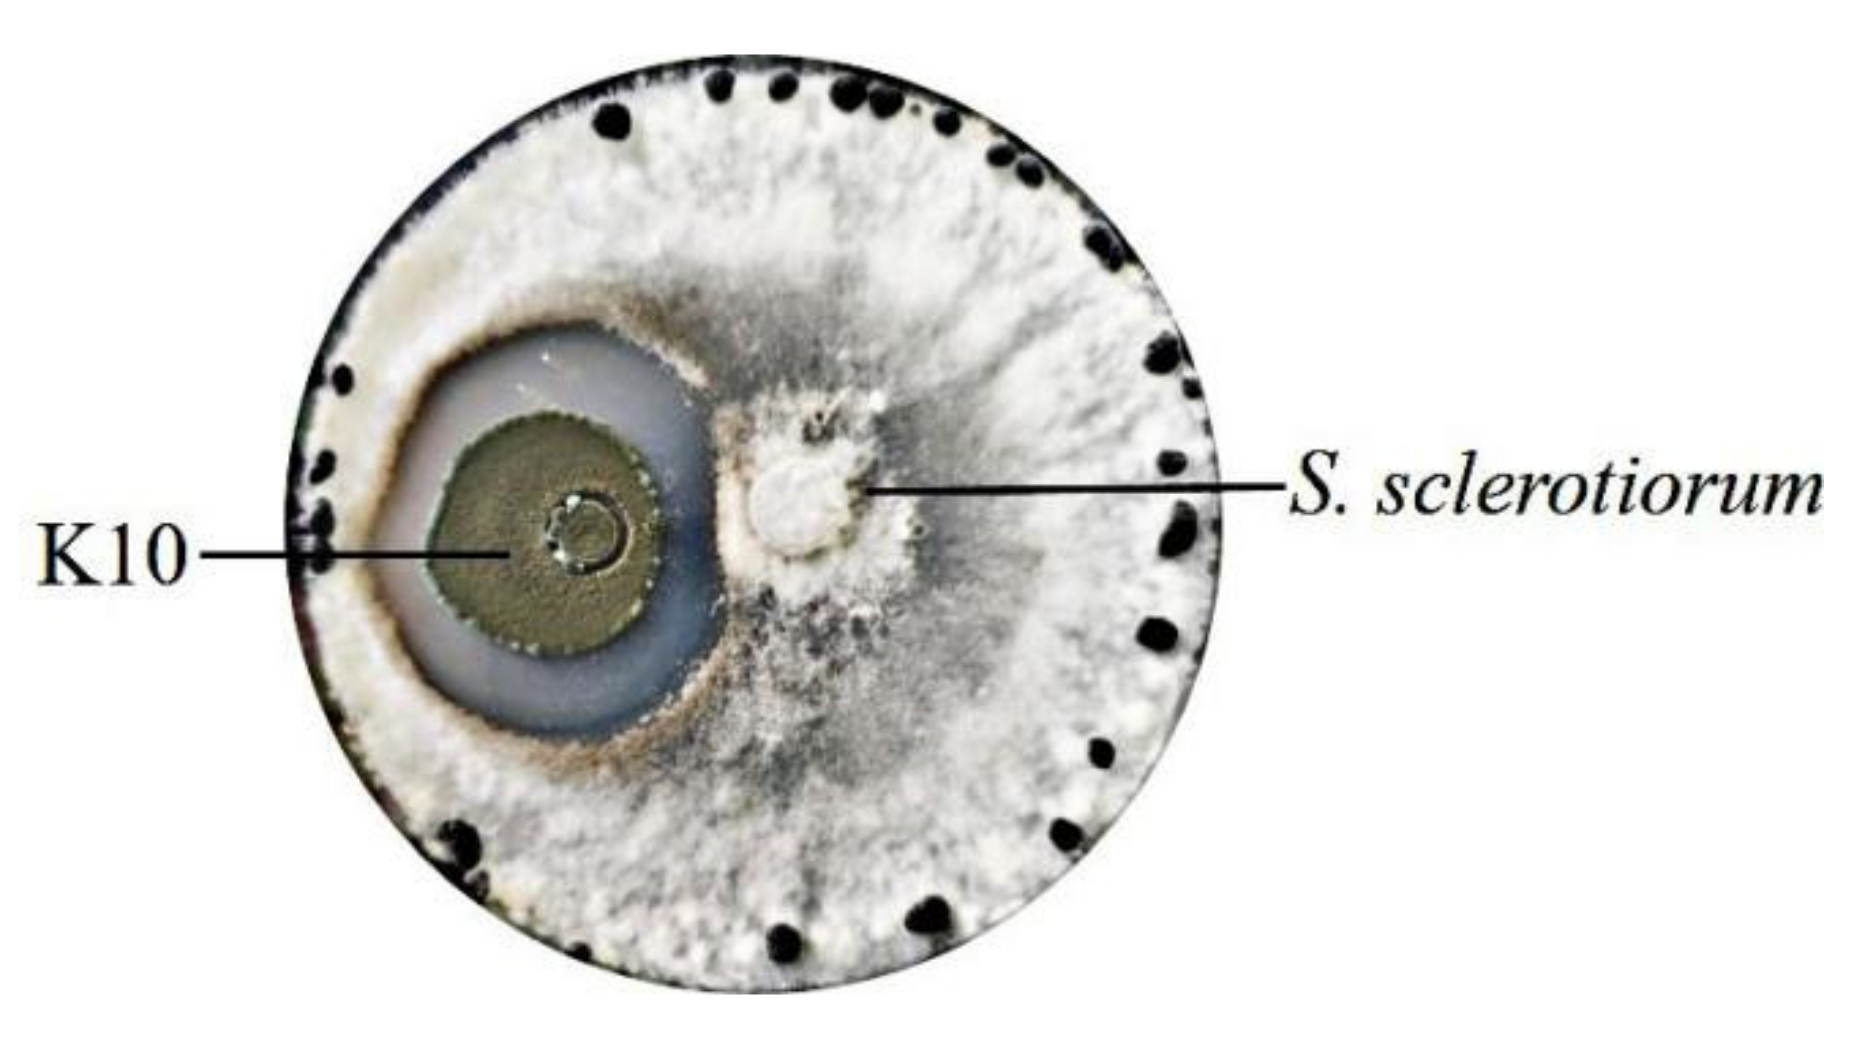
Marinedrugs 19 00356 g001
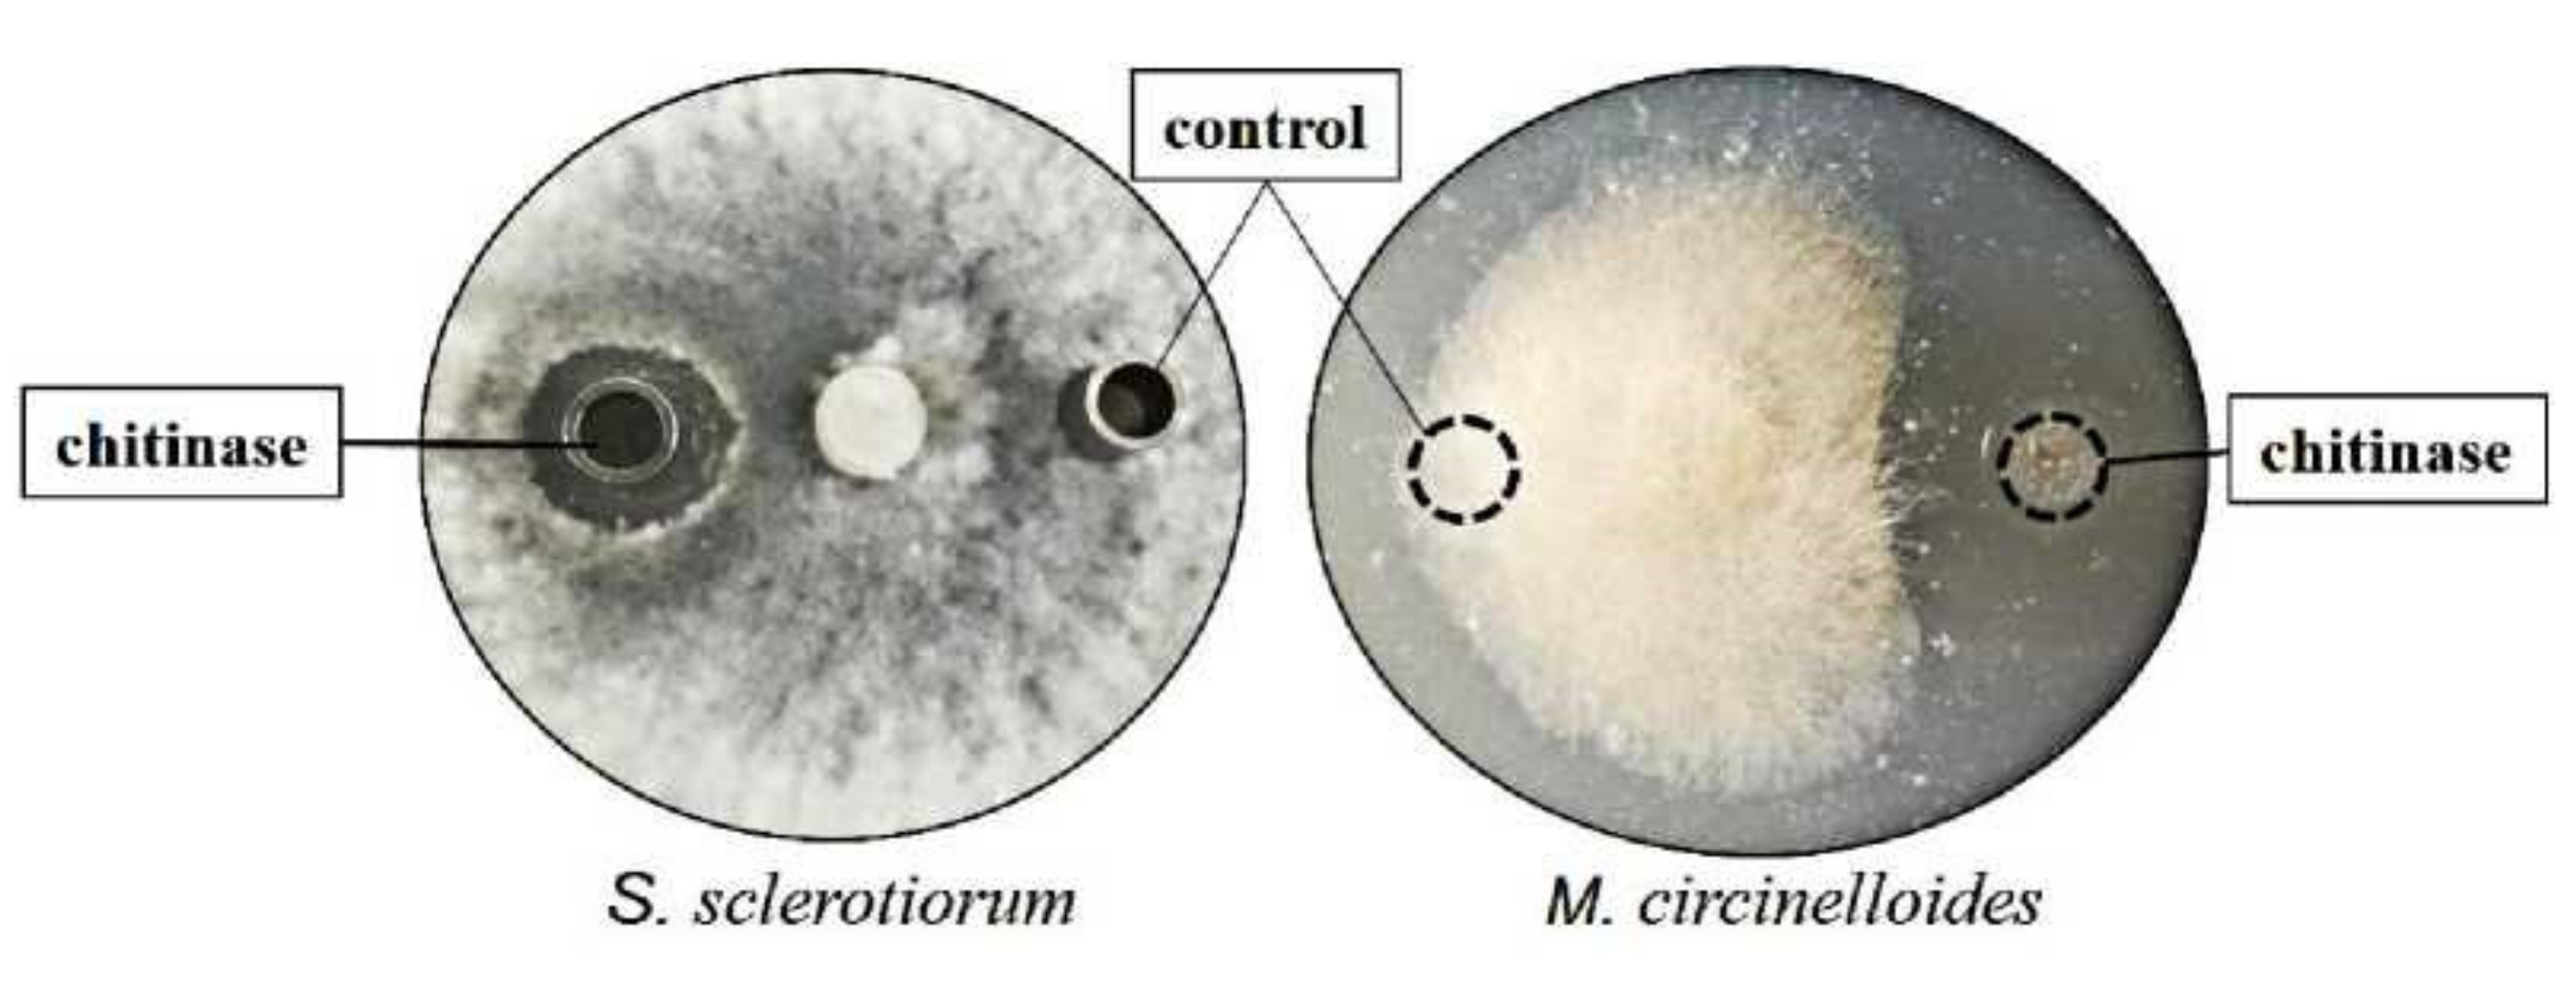
Marinedrugs 19 00356 g007

Abstract
Penicillium oxalicum k10 isolated from soil revealed the hydrolyzing ability of shrimp chitin and antifungal activity against Sclerotinia sclerotiorum. The k10 chitinase was produced from a powder chitin-containing medium and purified by ammonium sulfate precipitation and column chromatography. The purified chitinase showed maximal activity toward colloidal chitin at pH 5 and 40 °C. The enzymatic activity was enhanced by potassium and zinc, and it was inhibited by silver, iron, and copper. The chitinase could convert colloidal chitin to N-acetylglucosamine (GlcNAc), (GlcNAc)2, and (GlcNAc)3, showing that this enzyme had endocleavage and exocleavage activities. In addition, the chitinase prevented the mycelial growth of the phytopathogenic fungi S. sclerotiorum and Mucor circinelloides. These results indicate that k10 is a potential candidate for producing chitinase that could be useful for generating chitooligosaccharides from chitinous waste and functions as a fungicide.
1. Introduction
Chitin, a linear polysaccharide of N-acetylglucosamine (GlcNAc), is the major component of crustacean shell-waste material, insect exoskeletons, and fungal cell walls [1]. It is estimated that 1014 tons of chitin are produced every year in the shrimp and crab industry. Due to its highly ordered crystalline structure, chitin is insoluble in common solvents and has a low biodegradation rate by environmental microorganisms; thus, it has a negative impact on the environment, which limits its potential applications in the fields of food, medicine, and agriculture [2,3].
Chitin can be degraded into chitooligosaccharides (COSs), which are water-soluble, biocompatible, and non-toxic and exhibit a broad range of bioactivities, such as food preservation, dietary supplement, wound healing, anti-infection, antimicrobial, antioxidant, and plant growth-promoting properties [4,5,6], making them excellent alternatives. Therefore, the degradation of chitin biomass has become a hot research topic. Chitin can be converted into COSs through either chemical or enzymatic approaches. The enzymatic method, especially using chitinases, has the advantages of being environment friendly, needing mild reaction conditions, and resulting in well-defined COSs with high product safety [7].
Chitinases (EC 3.2.1.14) are hydrolytic enzymes that cleave the β-(1,4)-glycosidic bonds in chitin. These enzymes are widely distributed in fungi [8], bacteria [9], plants [10], and insects [11], and they play important roles to degradate chitinous waste for the production of oligosaccharides and GlcNAc [12,13]. They are also used in agriculture, food, and medicine for the biocontrol of pathogenic fungi [14]. However, it is expensive to use chitinases for the biodegradation of chitin and biocontrol due to its high production cost and low conversion rate [15]. As a result, there is an essential need for better chitinases for the enzymatic hydrolysis of chitin and biocontrol of fungi.
Recently, marine chitinases have attracted attention as one of the potential enzymes. The marine environment of chitinase-producing strains survival includes marine sediments and marine waste deposited soil along the coastal regions. In this study, we isolated the fungus Penicillium oxalicum from marine waste deposited soil, which can grow in medium containing shrimp chitin as a sole carbon source and has chitin-degrading activity. In addition, Sclerotinia sclerotiorum was used as a model for antagonistic evaluation, which was a devastating fungal plant pathogen with a broad host range (above 408 described species) [16]. Chitinase was optimally produced, and the biological characteristics were examined. Moreover, the applications of bioconversion of chitin and antifungal activity were carried out. Overall, our work aims at studying chitinolytic enzyme characteristics in order to obtain enzyme for industrial applications.
2. Results and Discussion
2.1. Isolation and Identification of Chitinase-Producing Strains
Chitinase can decompose chitin into simple molecules for cell applications. Furthermore, chitin is one of the major components of the fungal cell, and antifungal activity has been attributed to secreted chitinases lysing the fungal cell wall [17]. In our study, based on the above-mentioned properties, the chitinase-producing strains were isolated. Grown on powder chitin as the sole carbon source, the isolation of potent chitin-degrading strains was performed. Twenty fungus strains have been isolated from the shrimp waste disposal site, five of which showed high chitinase activity. The k10 strain produced the highest chitinase activity (4.2 U/mL). The k10 strain was used to further study the antagonistic property against S. sclerotiorum, which showed good inhibitory activity (Figure 1). For molecular identification, a 571 bp internal transcribed spacer (ITS) of k10 was sequenced and BLASTed. The results showed that k10 ITS exhibited 100% sequence identity to several P. oxalicum strains (GenBank Accession Nos. MT588795.1, MT529129.1, and MT446169.1
Figure 1.
Antagonistic property of k10 strain against the hyphal growth of S. sclerotiorum by a culture assay. The spore of the k10 strain was inoculated at a distance 1.5 cm away from the rim of the S. sclerotiorum colony and incubated at 28 °C.
2.2. Optimization of Culture Conditions for Chitinase Production
To investigate the effects of culture conditions on chitinase production by P. oxalicum k10, four chitinous materials and four nitrogen sources were used for fermentation. As shown in Figure 2A, colloidal chitin and powder chitin were the most suitable substrates for chitinase production with high activities. Thus, considering the production cost, powder chitin was chosen as an excellent inducer for further investigation. Figure 2B showed that tryptone was the most suitable nitrogen source for chitinase production. Additionally, basal medium containing 3% powder chitin and 4% tryptone were the most suitable for chitinase production at 28 °C and pH 5 for 3 days (Figure 2C–F). Furthermore, chitinase activity was influenced by carbon supplement in the production medium, which was observed with corn starch, and the activity peaked at 37 U/mL (Figure 2G).
Figure 2.
Effects of culture conditions on chitinase production by P. oxalicum k10: (A) Different inducer sources on chitinase production; (B) Different nitrogen sources on chitinase production; (C) Different concentrations (1–5%) of powder chitin on chitinase production at pH 6; (D) Different concentrations (1–8%) of tryptone on chitinase production at pH 6; (E) Effects of pH (2–9) on chitinase production at 28 °C; (F) Effects of temperature (24–34 °C) on chitinase production at pH 5; (G) Carbon sources supplement on chitinase production at 28 °C and pH 5.
Colloidal chitin was widely used as an inducer for the production of chitinase in various studies. For example, the expression of chitinases from Serratia marcescens PRNK-1 [18], Pedobacter sp. PR-M6 [19], and Bacillus licheniformis B307 [20] were incubated in 0.5% (w/v) colloidal chitin. Chitinases from Acremonium sp. YS2-2 [8], Trichoderma asperellum PQ34 [21], Myxococcus fulvus UM01 [22], and Achromobacter xylosoxidans [23] were induced in response to 1% colloidal chitin. The maximum chitinase yield of Trichoderma viride [24], Streptomyces pratensis KLSL55 [25], and Hydrogenophilus hirschii B-DZ44 [26] were obtained at 1.4%, 1.5%, and 2% of colloidal chitin, respectively. Colloidal chitin is a derivative of chitin obtained by acid–base chemical reagent (hydrogen chloride and sodium hydroxide) treatment; as a result, the production cost is high, and it leads to environmental pollution. To solve this problem, powder chitin and shrimp shell have been used to produce chitinolytic enzyme. An appropriate ratio of chitin and colloidal chitin resulted in an enhancement in chitinase production levels, and the optimum concentrations were 7.49 g/L chitin and 4.91 g/L colloidal chitin [27]. Bacillus altitudinis produced thermostable chitinase during a 4-day incubation on shrimp shell medium [28]. In our study, powder chitin was chosen as the inducer for chitinase production, which has the advantage of low cost for industrial application.
2.3. Chitinase Purification
The chitinase was effectively precipitated from the culture supernatant at a 70% concentration of ammonium sulfate. After the dialysis and Sephadex-75 size-exclusion chromatography, eight fractions containing enzyme activity were obtained. Approximately 190 mg k10 chitinase was obtained and the enzyme specific activity increased to 162.1 U/mg after purification using the Sephadex column (Table 1).
Table 1.
Estimation of P. oxalicum chitinase activity.
2.4. SDS-PAGE and Zymography
In culture supernatants from chitin-grown cells, one major protein band was detected (Figure 3, lane 2), with a molecular weight of approximately 45 kDa (Figure 3, lane 3); while for culture supernatants obtained from no chitin-grown cells, very low signal intensity was shown (Figure 3, lane 1). The chitinase activity of the protein was confirmed with zymography (Figure 3, lane 4).
Figure 3.
SDS-PAGE and zymography analyses of chitinase. Lanes: M, standard protein molecular weight markers; 1, culture supernatant of the control strain (no chitin inducer); 2, culture supernatant of the crude chitinase (2.6 μg); 3, purified chitinase (3.0 μg); 4, zymogram of the purified chitinase (2.0 μg).
2.5. Effects of Temperature and pH on Chitinase and Kinetic Parameters
After purification, the enzymatic characterization was determined. The purified chitinase exhibited maximum activity (100%) at 40 °C (Figure 4A). The activity of the enzyme remained above 90% for 60 min of incubation at 40 °C but decreased to 70% at 50 °C for 60 min and to 35% at 60 °C for 10 min (Figure 4B). The optimal temperature was similar to other chitinases from T. asperellum PQ34 [21], T. viride [24], Chitinibacter Tainanensis CT01 [29], and Bacillus subtilis [30].
Figure 4.
Enzymatic features of chitinase: (A) Temperature effects of chitinase toward colloidal chitin; (B) Thermostability of chitinase; (C) The pH effects of chitinase; (D) pH stability of chitinase. The data were presented as mean ± standard deviation of three biological replicates.
K10 chitinase was active in pH ranging between 4 and 7 and was found to have an optimal activity at pH of 5.0 (Figure 4C,D). A similar value was determined for the pH optimum of the chitinases from H. hirschii KB-DZ44 [26], B. subtilis [30], Streptomyces albolongus ATCC 27414 [31], and Chromobacterium violaceum [32].
The kinetic values of the chitinase were determined with colloidal chitin substrate, yielding Km of 12.56 mg/mL, kcat of 0.22 s−1, and Vmax of 1.05 μM min−1 mg−1 protein. An average activity during the 1st h was used to approximate initial activity and the enzyme activity was decreasing by 10% during 1 h assay.
2.6. Substrate Specificity of k10 Chitinase
To further investigate the features of the chitinase, substrate specificity was measured. The highest activity was defined as 100%. K10 chitinase had the maximum activity toward colloidal chitin (Table 2). Relative activity on powder chitin, ultrafine chitin, shrimp shell powder, and 90% deacetylated chitosan were 42.6%, 58.3%, 15.7%, and 11.4%, respectively, compared to colloidal chitin.
Table 2.
Substrate specificity of purified k10 chitinase.
2.7. Effects of Metal Ions and Chemical Reagents on Enzyme Activity
The effects of metal ions and chemical reagents on enzyme activity were determined. As shown in Table 3, the relative enzymatic activity was enhanced by zinc (Zn2+) and potassium (K+), and incubation with silver (Ag+), iron (Fe2+), sodium dodecyl sulfate (SDS), ethylenediaminetetraacetic acid (EDTA), and β-mercaptoethanol decreased the chitinolytic activity to 65.9%, 63.9%, 82.7%, 78.2%, and 75.8%, respectively. The addition of copper (Cu2+) and carbamide caused a decrease of >50% in chitinolytic activity. In other studies, K+ also increased the enzymatic activities from C. Tainanensis CT01 [29], Vibrio harveyi [33], and rChiT-7 [34]. Similarly, other chitinases were also inhibited by the addition of metal ions and chemical reagents. For example, ChiT-7 activity was suppressed by SDS, EDTA, Cu2+, and Ag+ [34]. S. marcescens chitinase was inhibited by Ag+, SDS, and Cu2+ [35]. Stenotrophomonas rhizophila G22 chitinase was inhibited by Fe2+, Cu2+, and SDS [36]. SaChiA4 activity was inhibited by Cu2+, EDTA, and SDS [31].
Table 3.
Effects of different metal ions and chemical reagents on the purified chitinase a.
2.8. Chitooligosaccharides (COSs) Preparation and Analysis of End Products
To study the effects of enzyme dosage on COSs yield, a varying amount of enzyme from 5 to 20 μg/mL was used. As expected, COSs yield increased with increasing enzyme concentration (Figure 5A). Then, 20 μg/mL chitinase was added to 20 mg/mL colloidal chitin and incubated from 6 to 48 h. After 30 h of treatment, the transparency of the reaction system was significantly increased, and the concentration of COSs peaked at 17 mg/mL (Figure 5B or Figure 6A). The end product of hydrolysis was analyzed by thin layer chromatography (TLC), and the most abundant oligosaccharides were (GlcNAc)2 and (GlcNAc)3, followed by GlcNAc (Figure 6B), indicating that k10 chitinase had endocleavage and exocleavage properties. Thus, k10 chitinase may be an ideal biocatalyst for the utilization of chitin biomass to produce COSs.
Figure 5.
(A) Yield of COSs with 5 to 20 μg/mL chitinase with 12 h treatment; (B) Yield of COSs from 20 mg/mL colloidal chitin degradation with 20 μg/mL chitinase added for 6 to 48 h.
Figure 6.
(A) Transparency of the reaction system between substrate and product (30 h treatment); (B) Analysis of the hydrolytic products of colloidal chitin by TLC. Lane M, the standard of (GlcNAc)n (n = 1–4); 1, control of chitin; 2, hydrolysate of chitin with 36 h treatment.
Chitinases are classified into two major categories. One category is endochitinases, which cleave chitin to generate soluble low-molecular (GlcNAc)n (n ≥ 2) [37]. For example, chitinases from Thermoascus aurantiacus, Chaetomium thermophilum, and S. marcescens exhibited an endocleavage pattern and hydrolyzed colloidal chitin to yield mainly (GlcNAc)2 [35,38]. rChit46 from Trichoderma harzianum effectively hydrolyzed chitin to produce (GlcNAc)2, (GlcNAc)3, and (GlcNAc)4 [39]. Chitinase from B. altitudinis hydrolyzed chitin to produce (GlcNAc)2, (GlcNAc)3, (GlcNAc)4, and (GlcNAc)5 [40]. Another chitinase category is exochitinases (beta-glucosaminidases and chitobiosidases), which cleave chitin or (GlcNAc)n to generate GlcNAc or (GlcNAc)2. For example, chitinases from Aeromonas caviae CHZ306 [41] and B. licheniformis AT6 [42] produced GlcNAc from chitin. Chitinases from Chitiniphilus shinanonensis [43] and Eiseniafetida [44] efficiently hydrolyzed colloidal chitin to release (GlcNAc)2.
However, at present, a few chitinases have the simultaneous catalytic activities of endochitinase and exochitinase, which are the so-called broad-specificity chitinases [45]. For example, chitinases from Paenibacillus timonensis LK-DZ15 [46] and Bacillus sp. DAU101 [9] cleaved colloidal chitin into a mixture of (GlcNAc)2, (GlcNAc)3, (GlcNAc)4, (GlcNAc)5, and GlcNAc. Chitinases from Humicola grisea [27] and Saccharothrix yanglingensis Hhs.015 [47] were capable of hydrolyzing chitin to (GlcNAc)3, (GlcNAc)2, and GlcNAc. Our results were similar to those of broad-specificity chitinases, and they showed endocleavage and exocleaveage activity, degrading colloidal chitin to produce (GlcNAc)3, (GlcNAc)2, and GlcNAc. Based on the catalytic mechanism, broad-specificity chitinases are more effective than single-activity chitinases, with obvious advantages of low cost and high catalytic efficiency on the degradation of chitin into COSs, which are good candidates for the green conversion of chitinous waste and have great valuable in the aspects of research and application.
2.9. Antifungal Activity of Chitinase
The antifungal activity of k10 chitinase against phytopathogenic fungi S. sclerotiorum and M. circinelloides was tested by the hyphal extension assay. As present in Figure 7, the inhibitory activity of k10 chitinase was observed compared to the control, which exhibited clear inhibitory zones of mycelial growth against S. sclerotiorum and M. circinelloides. These results indicate that the antagonistic property of k10 strain against S. sclerotiorum is related to its production of chitinase.
Figure 7.
Antifungal activity of purified enzyme produced from k10 against S. sclerotiorum and M. circinelloides after incubation on PDA medium. Control, thermo-denatured chitinase. Purified chitinase (2 μg) and control were added at a distance of 1.5 cm away from the rim of the mycelial colony, respectively, and incubated at 28 °C.
Since chitin is the key component of fungal cell walls, chitinases play an important role in plant defense against fungal pathogens. The antifungal activity of chitinases have been observed in diverse studies (Table 4). Similar to the reported chitinases, the antifungal activity of chitinase from P. oxalicum makes it a bioactive material for pathogenic fungi control in plant diseases and harmful food fungi.
Table 4.
Antifungal activity of chitinases toward various phytopathogenic fungus.
3. Materials and Methods
3.1. Chemicals
Shrimp shell chitin and chitosan were purchased from Sigma-Aldrich (St. Louis, MO, USA). (GlcNAc)n (n = 1–4) were purchased from BZ Oligo Biotech (Qingdao, Shandong Province, China). All other chemicals and solvents were acquired from local suppliers and were of analytical grade and high purity.
3.2. Preparation of Colloidal Chitin and Ultrafine Chitin
Colloidal chitin was prepared according to the method by Sandhya et al. [55] with a few modifications. Briefly, shrimp shell chitin and hydrogen chloride (37%, m/v) were mixed at a 1:5 ratio (w/v). After incubation at 4 °C overnight, the pH was adjusted to neutral with sodium hydroxide, tap water was added to the viscid solution, and the colloidal chitin was separated by centrifugation at 10,000 g and stored at 4 °C. Ultrafine chitin was prepared according to the method by Pareek et al. [56]. Chitin was dissolved in methanol with calcium chloride dihydrate overnight. Dissolved chitin was precipitated using calcium citrate solution; then, it was dialyzed and dried. Ultrafine chitin thus obtained was further treated with formic acid and dried.
3.3. Screening, Cultivation, and Identification of the Microbial Strain
The strains were isolated from soil from a shrimp waste disposal site surrounding a marine beach in Beihai Guangxi, China. The samples were inoculated on chitin powder (as a sole carbon source) agar medium containing powder chitin 10 g/L, (NH4)2SO4 1 g/L, K2HPO4 2 g/L, KH2PO4 1 g/L, NaCl 0.5 g/L, MgSO4 0.5 g/L, and agar 20 g/L, and incubated at 30 °C for 5 days. The strains that grew vigorously were picked. To evaluate the hydrolysis ability of chitin, strains were inoculated in medium containing chitin powder as a sole carbon source 10 g/L, tryptone 5 g/L, KH2PO4 1 g/L, K2HPO4 1 g/L, MgSO4 0.5 g/L, FeSO4 0.25 g/L, and NaCl 1 g/L, and then were cultivated for 120 h in a shaking incubator (200 rpm) at 28 °C. The supernatant was collected by centrifugation every 24 h during the 5-day cultivation period, and the chitinase activity was measured. To identify the fungi, a polymerase chain reaction (PCR) was performed to amplify the ITS gene from the genomic DNA. The forward primer was 5′-TCCGTAGGTGAACCTGCGG-3′, and the reverse primer was 5′-TCCTCCGCTTATTGATATGC-3′. The temperature cycle was at 94 °C for 30 s, 56 °C for 30 s, and 72 °C for 45 s for 35 cycles and 8 min at 72 °C for extension. The nucleotide sequence alignments were conducted using the BlastX program of NCBI (http://www.ncbi.nlm.nih.gov/BLAST (accessed on 24 November 2020)).
3.4. Antagonistic Activity Evaluation of Strain
For the evaluation of antagonistic activity, the S. sclerotiorum was preliminarily streaked on a potato dextrose agar (PDA) plate and incubated at 28 °C for 3 days. Then, 0.8 cm of the fungus colony on the PDA plate was cut and streaked on the center of a new PDA plate containing 1% colloidal chitin. The spore of the target strain was added to the agar plate, at a distance 1.5 cm away from the rim of the S. sclerotiorum colony. The plate was incubated at 28 °C and was observed for the appearance of a zone of fungal growth inhibition.
3.5. Determination of Chitinase Activity and Oligosaccharide Content
Chitinase activity was determined by the release of GlcNAc equivalents from colloidal chitin with a GlcNAc standard. The activity of chitinase on colloidal chitin was measured using the 3,5-dinitrosalicylic acid (DNS) assay [18] comprising 800 μL 1% colloidal chitin in 100 mM sodium acetate buffer (pH 5) and 200 μL enzyme. The mixture was incubated at 37 °C for 1 h. Then, the reaction was terminated by adding 1 mL DNS reagent and heating in boiling water for 10 min. The supernatant was collected by centrifugation. Next, 0.5 mL supernatant was mixed with 0.5 mL DNS and incubated at 100 °C for 10 min. The oligosaccharide content was estimated at 542 nm. One unit of chitinase activity was defined as the amount of enzyme that released one micromole of GlcNAc equivalent per min at 37 °C.
3.6. Optimization of Chitinase Production
To maximize chitinase production, the medium and process were optimized for shake flask cultures by one factor at a time. The strain was grown in basal medium (K2HPO4 5 g/L, MgSO4 2 g/L, FeSO4 1 g/L, NaCl 5 g/L), the induction of chitinase was checked by incorporating 1% inducer (colloidal chitin, powder chitin, shrimp shell powder, and chitosan), and the enzyme production was determined. Different nitrogen sources such as tryptone, peptone, beef extract, and soybean meal powder were chosen to compare chitinase production. The inducer and nitrogen source, which supported the maximum production of chitinase, were further tested at different concentrations for enhancement of enzyme production. The effects of pH and temperature were investigated by cultivating the test isolate in production medium at various pH (2–9) and temperature (24–34 °C) ranges. Carbon sources such as glucose, sucrose, cornstarch, and yeast extract were supplemented with the production medium to study their influence on chitinase activity.
3.7. Enzyme Purification
The cultures were centrifuged at 10,000 g for 10 min at 4 °C to obtain the supernatant, which served as the crude enzyme. The crude enzyme was precipitated with a 70% concentration of ammonium sulfate slowly added to the supernatant under constant stirring at 4 °C. The precipitate was collected by centrifuging at 10,000× g for 30 min at 4 °C and resuspended in Tris-HCl buffer (10 mM, pH 6.0). It was dialyzed against the same buffer for 24 h at 4 °C. Then, the dialyzed enzyme solution was purified with Sephadex 75 column (20 cm × 1.5 cm) pre-equilibrated with 3 column volumes of Tris-HCl buffer (10 mM, pH 6.0). The flow rate of 0.3 mL/min was used to elute the enzyme, and 0.6 mL/fraction/2 min was collected; in this way, 20 fractions were collected. The eluted fractions were assayed for chitinase activity. Fractions showing high chitinase activity were concentrated using a 30 kDa centricon Plus-20 (MILLIPORE). The purified enzyme was analyzed by gel electrophoresis and zymography, and the biochemical properties were determined.
3.8. Sodium Dodecyl Sulfate-Polyacrylamide Gel Electrophoresis and Zymography
Chitinase was resolved by sodium dodecyl sulfate-polyacrylamide gel electrophoresis (SDS-PAGE), and the protein bands were visualized with Coomassie brilliant blue R-250. Zymography was performed using the method by Yuli [57]. Briefly, chitinase protein, no cooking, and 2-mercaptoethanol were separated on a 12% polyacrylamide gel by incorporating 0.1% colloidal chitin. After electrophoresis, SDS removal, and rinsing, the gel was incubated in 50 mM Tris-HCl buffer (pH 5) at 37 °C for 12 h to allow the chitinase to hydrolyze the colloidal chitin substrate, and it was subsequently stained with 0.1% of Congo red solution followed by washing with 1 M NaCl. Then, the lytic zone was visualized.
3.9. Effects of Temperature and pH on Chitinase Activity and Stability
The temperature-dependent activity profile of purified chitinase activity was determined in 50 mM acetate buffer (pH 5.0) at temperatures from 30 to 60 °C. The pH activity profile of chitinase was determined at 40 °C and pH 3.0–10.0. For the thermal stability assay, the purified enzyme was pre-incubated at 40 °C, 50 °C, and 60 °C for 10–60 min, followed by the residual activity assay toward colloidal chitin. pH stability was determined by pre-incubating the purified enzyme at various pH using the same buffer system at 4 °C for 24 h, followed by the residual activity assay under standard conditions.
3.10. Kinetic Analysis of k10 Chitinase
Kinetic parameters of k10 chitinase were determined by incubating 1.0 μM of enzyme with different concentrations of colloidal chitin (0–20 mg/mL) in 100 mM sodium acetate buffer (pH 5) with respective controls in triplicates at 40 °C for 1 h. The reducing ends generated were measured by chitinase assay as described in Section 3.5. Kinetic parameters were evaluated from three independent sets of data fitting to the Michaelis–Menten equation by nonlinear regression function using GraphPad Prism version 5.0 (GraphPad Software, San Diego, CA, USA).
3.11. Substrate Specificity Determination
The substrate specificity of purified k10 chitinase was tested under standard conditions (40 °C, pH 5.0 for 1 h) with 1% (w/v) of colloidal chitin, shrimp chitin powder, ultrafine chitin, shrimp shell powder, 90% deacetylated chitosan, and cellulose as the substrate.
3.12. Effects of Metal Ions and Chemical Reagents on Enzyme Activity
The effects of metal ions and chemical reagents on chitinase were investigated by measuring the enzyme activity in the presence of 10 mM K+, Mg2+, Fe2+, Cu2+, Na+, Ca2+, Zn2+, Ag+, carbamide, EDTA, β-mercaptoethanol, and SDS. The activities of untreated enzyme were defined as 100%.
3.13. Preparation of COSs
To study the best combination of the reaction time and enzyme dosage, a 2 mL reaction mixture consisting of 5–20 μg/mL enzyme for each experimental and 20 mg/L colloidal chitin in 100 mM sodium acetate buffer (pH 5.0) was incubated at 40 °C. Aliquots were analyzed for hydrolyzed products at different time intervals.
3.14. Thin Layer Chromatography Analysis of end Products of Hydrolysis
The end products of hydrolysis were separated on a glass-backed TLC Aluminum Silica Gel Plate (Merck, Darmstadt, Germany) in a solvent system containing iso-propanol/ethanol/water/ammonia at the ratio of 5:5:4:0.3 (v/v/v/v) as the mobile phase. (GlcNAC)n (n = 1–4) was used as the standard. The plate was dried and sprayed with 0.5% ninhydrin reagent (0.5 g ninhydrin dissolved in 100 mL ethanol), followed by incubation at 115 °C to develop the signal.
3.15. Assay for Antifungal Activity of Chitinase
The antifungal activities of k10 chitinase were tested by employing a hyphal extension inhibition assay as previously described [58]. Then, 0.8 cm of the S. sclerotiorum and M. circinelloides fungal colonies were transferred to the PDA plate and incubated until fungal growth was observed. Sterile oxford cups were placed on the plate at a distance of 1.5 cm away from the rim of the mycelial colony, after which purified chitinase (filtered with pore size of 0.22 um) and control (thermo-denatured chitinase) were added. The plates were incubated at 28 °C until mycelial growth had enveloped the wells containing formed zones of inhibition around the cups containing chitinase with antifungal activity.
3.16. Statistical Analysis
All data were shown as the mean of at least three independent replicates with their standard deviations. GraphPad Prism 5.0 was used for statistical analysis, and the treatments with a p value of less than 0.05 were considered to be statistically significant.
4. Conclusions
A P. oxalicum k10 strain capable of degrading chitin and showing chitinase activity was isolated. The production of chitinase by k10 degrading powder chitin was demonstrated. The K+ and Zn2+ were promoters of chitinase activity, and Cu2+, Fe2+, Ag+, carbamide, EDTA, β-mercaptoethanol, and SDS were inhibitors. TLC results showed that k10 chitinase had endocleavge and exocleavage properties. The major enzymolysis end products were (GlcNAc)2, (GlcNAc)3, and a small amount of GlcNAc. Furthermore, the chitinase exhibited clear inhibitory of mycelial growth against S. sclerotiorum and M. circinelloides. These results reveal that P. oxalicum chitinase is a good candidate as a bioconversion agent of chitinous waste and can be exploited as a fungicide.
Author Contributions
Conceptualization, X.-H.X., W.-F.P. and L.-X.K.; methodology, X.-H.X., X.F., X.-Y.Y. and L.-X.K.; investigation, X.-H.X., X.F. and X.-Y.Y.; resources, W.-F.P. and L.-X.K.; writing—original draft preparation, X.-H.X. and X.F.; writing—review and editing, W.-F.P. and L.-X.K.; supervision, W.-F.P. and L.-X.K.; project administration, L.-X.K.; funding acquisition, W.-F.P. and L.-X.K. All authors have read and agreed to the published version of the manuscript.
Funding
This work was supported by Youth Fund Project of Hubei Provincial Department of Education (No. Q20161007) and Natural Science Foundation of Hubei Province, China (No. 2017CFB538).
Institutional Review Board Statement
Not applicable.
Informed Consent Statement
Not applicable.
Conflicts of Interest
The authors declare no competing financial interests.
References
- Lacombe-Harvey, M.E.; Brzezinski, R.; Beaulieu, C. Chitinolytic functions in actinobacteria: Ecology, enzymes, and evolution. Appl. Microbiol. Biotechnol. 2018, 102, 7219–7230. [Google Scholar] [CrossRef] [PubMed]
- Souza, C.P.; Almeida, B.C.; Colwell, R.R.; Rivera, I.N.G. The importance of chitin in the marine environment. Mar. Biotechnol. 2011, 13, 823–830. [Google Scholar] [CrossRef] [PubMed]
- Dhillon, G.S.; Kaur, S.; Brar, S.K.; Verma, M. Green synthesis approach: Extraction of chitosan from fungus mycelia. Crit. Rev. Biotechnol. 2012, 33, 379–403. [Google Scholar] [CrossRef]
- Bak, Y.K.; Lampe, J.W.; Sung, M.K. Effects of dietary supplementation of glucosamine sulfate on intestinal inflammation in a mouse model of experimental colitis. J. Gastroen. Hepatol. 2014, 29, 957–963. [Google Scholar] [CrossRef] [PubMed]
- Chen, J.K.; Shen, C.R.; Liu, C.L. N-acetylglucosamine: Production and applications. Mar. Drugs 2010, 8, 2493–2516. [Google Scholar] [CrossRef]
- Dalirfardouei, R.; Karimi, G.; Jamialahmadi, K. Molecular mechanisms and biomedical applications of glucosamine as a potential multifunctional therapeutic agent. Life Sci. 2016, 152, 21–29. [Google Scholar] [CrossRef] [PubMed]
- Kudan, S.; Eksittikul, T.; Pichyangkura, R.; Park, R.D. Preparation of N-acetyl-D-glucosamine and N, N’-acetylchitobiose by enzymatic hydrolysis of chitin with crude chitinases. J. Biotechnol. 2010, 150, 89. [Google Scholar] [CrossRef]
- Chung, D.; Baek, K.; Bae, S.S.; Jung, J. Identification and characterization of a marine-derived chitinolytic fungus, Acremonium sp. YS2-2. J. Microbiol. 2019, 57, 372–380. [Google Scholar] [CrossRef]
- Pan, M.; Li, J.; Lv, X.; Du, G.; Liu, L. Molecular engineering of chitinase from Bacillus sp. DAU101 for enzymatic production of chitooligosaccharides. Enzyme Microb. Technol. 2019, 124, 54–62. [Google Scholar] [CrossRef]
- Song, Y.S.; Lee, S.H.; Cho, J.A.; Moon, C.; Seo, D.J.; Jung, W.J. Expression and degradation patterns of chitinase purified from Xuehuali (Pyrus bretschneiderilia) pollen. Int. J. Biol. Macromol. 2018, 107, 446–452. [Google Scholar] [CrossRef]
- Mahmood, S.; Kumar, M.; Kumari, P.; Mahapatro, G.K.; Sarin, N.B. Novel insecticidal chitinase from the insect pathogen Xenorhabdus nematophila. Int. J. Biol. Macromol. 2020, 159, 394–401. [Google Scholar] [CrossRef]
- Zhu, W.; Wang, D.; Liu, T.; Yang, Q. Production of N-acetyl-D-glucosamine from mycelial waste by a combination of bacterial chitinases and an insect Nacetyl-D-glucosaminidase. J. Agric. Food Chem. 2016, 64, 6738–6744. [Google Scholar] [CrossRef]
- Monge, E.C.; Tuveng, T.R.; Vaaje-Kolstad, G.; Eijsink, V.G.; Gardner, J.G. Systems analysis of the family glycoside hydrolase family 18 enzymes from Cellvibrio japonicus characterizes essential chitin degradation functions. J. Biol. Chem. 2018, 293, 3849–3859. [Google Scholar] [CrossRef] [PubMed]
- Han, J.H.; Park, G.C.; Kim, K.S. Antagonistic evaluation of Chromobacterium sp. JH7 for biological control of ginseng root rot caused by Cylindrocarpon destructans. Mycobiology 2017, 45, 370–378. [Google Scholar] [CrossRef]
- Jung, W.J.; Park, R.D. Bioproduction of chitooligosaccharides: Present and perspectives. Mar. Drugs 2014, 12, 5328–5356. [Google Scholar] [CrossRef]
- Boland, G.J.; Hall, R. Index of plant hosts of Sclerotinia sclerotiorum. Can. J. Plant Pathol. 1994, 16, 93–108. [Google Scholar] [CrossRef]
- Park, S.K.; Lee, M.C.; Harman, G.E. The Biocontrol Activity of Chromobacterium sp. Strain C-61 against Rhizoctonia solani Depends on the Productive Ability of Chitinase. Plant Pathol. J. 2005, 21, 275–282. [Google Scholar] [CrossRef]
- Moon, C.; Seo, D.J.; Song, Y.S.; Hong, S.H.; Choi, S.H.; Jung, W.J. Antifungal activity and patterns of N-acetyl-chitooligosaccharide degradation via chitinase produced from Serratia marcescens PRNK-1. Microb. Pathog. 2017, 113, 218–224. [Google Scholar] [CrossRef]
- Song, Y.S.; Seo, D.J.; Jung, W.J. Identification, purification, and expression patterns of chitinase from psychrotolerant Pedobacter sp. PR-M6 and antifungal activity in vitro. Microb. Pathog. 2017, 107, 62–68. [Google Scholar] [CrossRef] [PubMed]
- Akeed, Y.; Atrash, F.; Naffaa, W. Partial purification and characterization of chitinase produced by Bacillus licheniformis B307. Heliyon 2020, 6, e03858. [Google Scholar] [CrossRef]
- Loc, N.H.; Huy, N.D.; Quang, H.T.; Lan, T.T.; Ha, T.T.T. Characterisation and antifungal activity of extracellular chitinase from a biocontrol fungus, Trichoderma asperellum PQ34. Mycology 2020, 11, 38–48. [Google Scholar] [CrossRef] [PubMed]
- Shahbaz, U.; Yu, X. Cloning, isolation, and characterization of novel chitinase-producing bacterial strain UM01 (Myxococcus fulvus). J. Gen. Eng. Biotechnol. 2020, 18, 45. [Google Scholar] [CrossRef]
- Subramanian, K.; Sadaiappan, B.; Aruni, W.; Kumarappan, A.; Thirunavukarasu, R.; Srinivasan, G.P.; Bharathi, S.; Nainangu, P.; Renuga, P.S.; Elamaran, A.; et al. Bioconversion of chitin and concomitant production of chitinase and N-acetylglucosamine by novel Achromobacter xylosoxidans isolated from shrimp waste disposal area. Sci. Rep. 2020, 10, 11898. [Google Scholar] [CrossRef] [PubMed]
- Medhat, A.A.-T.; George, S.I. Anticancer and antifungal efficiencies of purified chitinase produced from Trichoderma viride under submerged fermentation. J. Gen. Appl. Microbiol. 2020, 66, 32–40. [Google Scholar]
- Shivalee, A.; Lingappa, K.; Mahesh, D. Influence of bioprocess variables on the production of extracellular chitinase under submerged fermentation by Streptomyces pratensis strain KLSL55. J. Gen. Eng. Biotechnol. 2018, 16, 421–426. [Google Scholar] [CrossRef] [PubMed]
- Bouacem, K.; Laribi-Habchi, H.; Mechri, S.; Hacenea, H.; Jaouadi, B.; Bouanane-Darenfed, A. Biochemical characterization of a novel thermostable chitinase from Hydrogenophilus hirschii strain KB-DZ44. Int. J. Biol. Macromol. 2018, 106, 338–350. [Google Scholar] [CrossRef]
- Kumar, M.; Brar, A.; Vivekanand, V.; Pareek, N. Production of chitinase from thermophilic Humicola grisea and its application in production of bioactive chitooligosaccharides. Int. J. Biol. Macromol. 2017, 104, 1641–1647. [Google Scholar] [CrossRef]
- Abassi, S.; Emtiazi, G.; HosseiniAbari, A.; Kim, B.G. Chitooligosaccharides and Thermostable Chitinase against Vulvovaginal Candidiasis and Saprophyte Fungi: LC Mass Studies of Shrimp Shell Fermentation by Bacillus altitudinis. Curr. Microbiol. 2020, 77, 40–48. [Google Scholar] [CrossRef]
- Wang, Y.T.; Wu, P.L. Gene Cloning, Characterization, and Molecular Simulations of a Novel Recombinant Chitinase from Chitinibacter Tainanensis CT01 Appropriate for Chitin Enzymatic Hydrolysis. Polymers 2020, 12, 1648. [Google Scholar] [CrossRef]
- Wang, D.; Li, A.; Han, H.; Liu, T.; Yang, Q. A potent chitinase from Bacillus subtilis for the efficient bioconversion of chitin-containing wastes. Int. J. Biol. Macromol. 2018, 116, 863–868. [Google Scholar] [CrossRef]
- Li, G.; Sun, J.; Secundo, F.; Xin, G.; Xue, C.; Mao, X. Cloning, characterization and substrate degradation mode of a novel chitinase from Streptomyces albolongus ATCC 27414. Food Chem. 2018, 261, 329–336. [Google Scholar]
- Sousa, A.J.; Silva, C.F.; Sousa, J.S.; Júnior, J.E.M.; Freire, J.E.; Sousa, B.L.; Lobo, M.D.; Monteiro-Moreira, A.C.; Grangeiro, T.B. A thermostable chitinase from the antagonistic Chromobacterium violaceum that inhibits the development of phytopathogenic fungi. Enzyme Microb. Technol. 2019, 126, 50–61. [Google Scholar] [CrossRef]
- He, X.X.; Yu, M.; Wu, Y.H.; Ran, L.M.; Liu, W.Z.; Zhang, X.H. Two Highly Similar Chitinases from Marine Vibrio Species have Different Enzymatic Properties. Mar. Drugs 2020, 18, 139. [Google Scholar] [CrossRef] [PubMed]
- Li, R.K.; Hu, Y.J.; Ng, T.B.; Guo, B.Q.; Zhou, Z.H.; Zhao, J.; Ye, X.Y. Expression and biochemical characterization of a novel chitinase ChiT-7 from the metagenome in the soil of a mangrove tidal flat in China. Int. J. Biol. Macromol. 2020, 158, 1125–1134. [Google Scholar] [CrossRef]
- Li, J.; Zheng, J.; Liang, Y.; Yan, R.; Xu, X.; Lin, J. Expression and characterization of a chitinase from Serratia marcescens. Protein Expres. Purif. 2020, 171, 105613. [Google Scholar] [CrossRef]
- Jankiewicz, U.; Baranowski, B.; Swiontek Brzezinska, M.; Frak, M. Purifcation, characterization and cloning of a chitinase from Stenotrophomonas rhizophila G22. 3 Biotech. 2020, 10, 16. [Google Scholar] [CrossRef]
- Patil, R.S.; Ghormade, V.; Deshpande, M.V. Chitinolytic enzymes: An exploration. Enzyme Microb. Technol. 2000, 26, 473–483. [Google Scholar] [CrossRef]
- Li, A.N.; Yu, K.; Liu, H.Q.; Zhang, J.; Li, H.; Li, D.C. Two novel thermostable chitinase genes from thermophilic fungi: Cloning, expression and characterization. Bioresour. Technol. 2010, 101, 5546–5551. [Google Scholar] [CrossRef] [PubMed]
- Deng, J.J.; Shi, D.; Mao, H.H.; Li, Z.W.; Liang, S.; Ke, Y.; Luo, X.C. Heterologous expression and characterization of an antifungal chitinase (Chit46) from Trichoderma harzianum GIM 3.442 and its application in colloidal chitin conversion. Int. J. Biol. Macromol. 2019, 134, 113–121. [Google Scholar] [CrossRef]
- Asmani, K.L.; Bouacem, K.; Ouelhadj, A.; Yahiaoui, M.; Bechami, S.; Mechri, S.; Jabeur, F.; Menguellet, K.T.A.; Jaouadi, B. Biochemical and molecular characterization of an acido-thermostable endo-chitinase from Bacillus altitudinis KA15 for industrial degradation of chitinous waste. Carbohydr. Res. 2020, 495, 108089. [Google Scholar] [CrossRef] [PubMed]
- Cardozo, F.A.; Facchinatto, W.M.; Colnago, L.A.; Campana-Filho, S.P.; Pessoa, A. Bioproduction of N-acetyl-glucosamine from colloidal α-chitin using an enzyme cocktail produced by Aeromonas caviae CHZ306. World J. Microbiol. Biotechnol. 2019, 35, 114. [Google Scholar] [CrossRef]
- Aounallah, M.A.; Slimene-Debez, I.B.; Djebali, K.; Gharbi, D.; Hammami, M.; Azaiez, S.; Limam, F.; Tabbene, O. Enhancement of Exochitinase Production by Bacillus licheniformis AT6 Strain and Improvement of N-Acetylglucosamine Production. Appl. Biochem. Biotechnol. 2017, 181, 650–666. [Google Scholar] [CrossRef]
- Rani, T.S.; Madhuprakash, J.; Podile, A.R. Chitinase-E from Chitiniphilus shinanonensis generates chitobiose from chitin flakes. Int. J. Biol. Macromol. 2020, 163, 1037–1043. [Google Scholar] [CrossRef]
- Uedaa, M.; Shioyamaa, T.; Nakadoia, K.; Nakazawaa, M.; Sakamotoa, T.; Iwamotob, T.; Sakaguchi, M. Cloning and expression of a chitinase gene from Eisenia fetida. Int. J. Biol. Macromol. 2017, 104, 1648–1655. [Google Scholar] [CrossRef] [PubMed]
- Vrzheshch, P. Steady-state kinetics of bifunctional enzymes. Taking into account kinetic hierarchy of fast and slow catalytic cycles in a generalized model. Biochemistry 2007, 72, 936–943. [Google Scholar] [CrossRef]
- Yahiaoui, M.; Laribi-Habchi, H.; Bouacem, K.; Asmani, K.L.; Mechri, S.; Harir, M.; Bendif, H.; AEl Fertas, R.; Jaouadi, B. Purification and biochemical characterization of a new organic solventtolerant chitinase from Paenibacillus timonensis strain LK-DZ15 isolated from the Djurdjura Mountains in Kabylia, Algeria. Carbohydr. Res. 2019, 483, 107747. [Google Scholar] [CrossRef] [PubMed]
- Lu, Y.Y.; Wang, N.N.; He, J.; Li, Y.F.; Gao, X.N.; Huang, L.L.; Yan, X. Expression and characterization of a novel chitinase with antifungal activity from a rare actinomycete, Saccharothrix yanglingensis Hhs.015. Protein Expres. Purif. 2018, 143, 45–51. [Google Scholar] [CrossRef]
- Shehata, A.N.; Abd el Aty, A.A.; Darwish, D.A.; Abdel Wahab, W.A.; Mostafa, F.A. Purification, physicochemical and thermodynamic studies of antifungal chitinase with production of bioactive chitosan-oligosaccharide from newly isolated Aspergillus griseoaurantiacus KX010988. Int. J. Biol. Macromol. 2017, 107, 990–999. [Google Scholar] [CrossRef]
- Hong, S.H.; Song, Y.S.; Seo, D.J.; Kim, K.Y.; Jung, W.J. Antifungal activity and expression patterns of extracellular chitinase and beta-1,3-glucanase in Wickerhamomyces anomalus EG2 treated with chitin and glucan. Microb. Pathog. 2017, 110, 159–164. [Google Scholar] [CrossRef] [PubMed]
- Rishad, K.S.; Rebello, S.; Shabanamol, P.S.; Jisha, M.S. Biocontrol potential of Halotolerant bacterial chitinase from high yielding novel Bacillus Pumilus MCB-7 autochthonous to mangrove ecosystem. Pestic. Biochem. Phys. 2017, 137, 36–41. [Google Scholar] [CrossRef]
- Kim, Y.H.; Park, S.K.; Hur, J.Y.; Kim, Y.C. Purification and Characterization of a Major Extracellular Chitinase from a Biocontrol Bacterium, Paenibacillus elgii HOA73. Plant Pathol. J. 2017, 33, 318–328. [Google Scholar] [CrossRef]
- Le, B.; Yang, S.H. Characterization of a chitinase from Salinivibrio sp. BAO-1801 as an antifungal activity and a biocatalyst for producing chitobiose. J. Basic. Microbiol. 2018, 58, 848–856. [Google Scholar] [CrossRef]
- Castillo, B.M.; Dunn, M.F.; Navarro, K.G.; Melendez, F.H.; Ortiz, M.H.; Guevara, S.E.; Palacios, G.H. Antifungal performance of extracellular chitinases and culture supernatants of Streptomyces galilaeus CFFSUR-B12 against Mycosphaerella fijiensis Morelet. World J. Microbiol. Biotechnol. 2016, 32, 44. [Google Scholar] [CrossRef] [PubMed]
- Han, P.; Yang, C.; Liang, X.; Li, L. Identification and characterization of a novel chitinase with antifungal activity from ‘Baozhu’ pear (Pyrus ussuriensis Maxim.). Food Chem. 2016, 196, 808–814. [Google Scholar] [CrossRef] [PubMed]
- Sandhya, C.; Adapa, L.K.; Nampoothiri, K.M.; Binod, P.; Szakacs, G.; Pandey, A. Extracellular chitinase production by Trichoderma harzianum in submerged fermentation. J. Basic Microbiol. 2010, 44, 49–58. [Google Scholar] [CrossRef] [PubMed]
- Pareek, N.; Vivekanand, V.; Agarwal, P.; Saroj, S.; Singh, R.P. Bioconversion to chitosan: A two stage process employing chitin deacetylase from Penicillium oxalicum SAEM-51. Carbohydr. Polym. 2013, 96, 417–425. [Google Scholar] [CrossRef] [PubMed]
- Yuli, P.E.; Suhartono, M.T.; Rukayadi, Y.; Hwang, J.K.; Pyun, Y.R. Characteristics of thermostable chitinase enzymes from the indonesian Bacillus sp. 13.26. Enzyme Microb. Technol. 2004, 35, 147–153. [Google Scholar] [CrossRef]
- Mehmood, M.A.; Xiao, X.; Hafeez, F.Y.; Gai, Y.; Wang, F. Molecular characterization of the modular chitin binding protein Cbp50 from Bacillus thuringiensis serovar konkukian. Antonie Van Leeuwenhoek. 2011, 100, 445–453. [Google Scholar] [CrossRef]
Publisher’s Note: MDPI stays neutral with regard to jurisdictional claims in published maps and institutional affiliations. |
© 2021 by the authors. Licensee MDPI, Basel, Switzerland. This article is an open access article distributed under the terms and conditions of the Creative Commons Attribution (CC BY) license (https://creativecommons.org/licenses/by/4.0/).